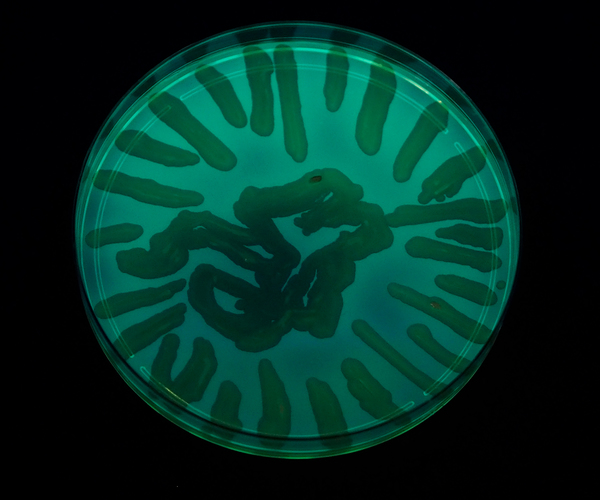

Dni Otwarte GUMed 2024 za nami
18.04.2024
Kilka tysięcy osób odwiedziło Gdański Uniwersytet Medyczny w dniach 11-12 kwietnia br. podczas Dni Otwartych. Tegoroczne spotkanie trwało dwa dni i skupiło uwagę zarówno przyszłych studentów, jak i tych, którzy chcieli pogłębić swoją wiedzę na temat dziedzin medycznych. Zebranych uczestników przywitali prof. Marcin Gruchała, rektor GUMed, prof. Edyta Szurowska, prorektor ds. klinicznych GUMed oraz dr hab. Tomasz Smiatacz, prorektor ds. studenckich GUMed. Wykład inauguracyjny pt. Tylko nie na medycynę! Kto powinien zostać medykiem? wygłosił dr hab. Michał Brzeziński, prof. uczelni z Katedry i Kliniki Pediatrii, Gastroenterologii, Alergologii i Żywienia Dzieci GUMed.

Ponad 60 stoisk z pokazami i warsztatami, bogaty program wykładów oraz możliwość czynnego udziału w quizach i eksperymentach przyciągnęły uczestników z całej Polski. Rozlokowanie wydarzenia w czterech lokalizacjach umożliwiło obecnym łatwy dostęp i maksymalne wykorzystanie czasu podczas Dni Otwartych. Różnorodność miejsc spotkań dodatkowo ułatwiła uczestnikom zapoznanie się z infrastrukturą Uczelni oraz atmosferą panującą na jej terenie.
Dzięki zaangażowaniu członków Studenckich Kół Naukowych oraz prezentacji naukowców i studentów uczestnicy mieli unikatową okazję do zapoznania się z szeroką gamą praktycznych umiejętności, od nauki szycia ran po pierwszą pomoc. Dodatkowo, stoiska tematyczne na Wydziale Farmaceutycznym dostarczyły wiedzy na temat produkcji leków, zastosowań druku 3D w farmacji czy suplementacji diety. Organizatorzy zaprosili zwiedzających na pokazy sporządzania maści i kapsułek, na kolorowe eksperymenty, do oglądania preparatów pod mikroskopem czy do odkrywania tajników otrzymywania i oczyszczania ważnych substancji leczniczych.

Wydarzenie było nie tylko okazją do zdobycia wiedzy i doświadczenia, ale także integracji społeczności akademickiej oraz potencjalnych przyszłych studentów.
fot. Paweł Sudara/GUMed i Agata Zygadło/GUMed
Archiwum
- Rok akademicki 2024/2025
- Rok akademicki 2023/2024
- Rok akademicki 2022/2023
- Rok akademicki 2021/2022
- Rok akademicki 2020/2021
- Rok akademicki 2019/2020
- Rok akademicki 2018/2019
- Rok akademicki 2017/2018
- Rok akademicki 2016/2017
- Rok akademicki 2015/2016
- Rok akademicki 2014/2015
- Rok akademicki 2013/2014
- Rok akademicki 2012/2013
- Rok akademicki 2011/2012
- Rok akademicki 2010/2011
- Rok akademicki 2009/2010
- Rok akademicki 2008/2009
- Rok akademicki 2007/2008
- Inauguracje roku akademickiego